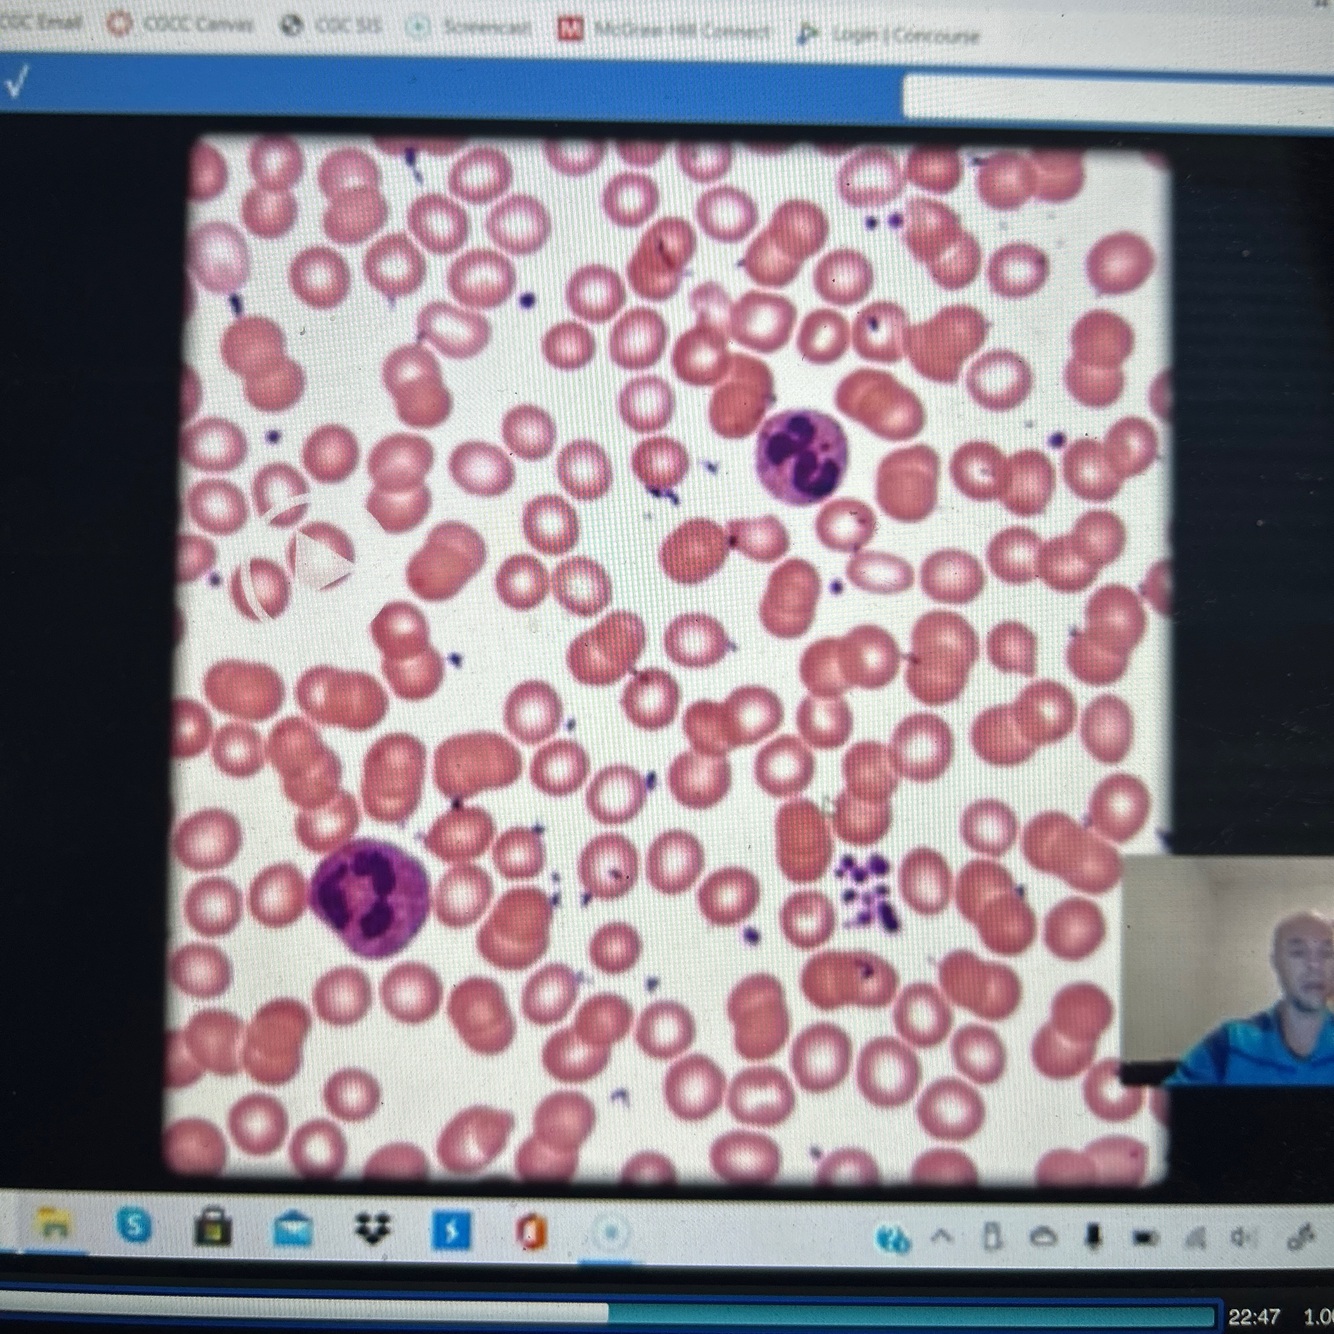

Name the tissue type and any extra parts that you see.


Name the tissue type and any extra parts that you see.


Name the tissue type and any extra parts that you see.


Name the tissue type and any extra parts that you see.


Name the tissue type and any extra parts that you see.
Location and function?

Keratinized stratified squamous epithelia
Skin
Protection

Name the tissue type and any extra parts that you see.
Location and function?

Transitional epithelia
Bladder
Stretch to fill with urine

Name the tissue type and any extra parts that you see.
Location and functions?

Non- keritinized stratified squamous epithelium
Mouth, tongue, vagina, anus

Name the tissue type and any extra parts that you see.
Location and function?

Areolar connective tissue
Found underneath epithelia
Support

Name the tissue type and any extra parts that you see.

Adipose tissue
Everywhere In and around organs, under skin, surrounds organs
Insulate, protect, fuel reserve

Name the tissue type and any extra parts that you see.
Location and function?

Reticular tissue (made of fibroblasts)
Support lymph organs
Lymph nodes

Name the tissue type and any extra parts that you see.
Location and function?

Dense regular tissue
Tendons and ligaments
Strength and Supports connections bone-bones and muscle-bones

Name the tissue type and any extra parts that you see.
Location and function?

Dense irregular
Dermis
Provide strength and resilience in many directions

Name the cartilage
Give function and location
Identify pericondrium, lacunae, condrocytes

Hyaline cartilage
ends of long bones, rib (costal cartilage), nose, trachea
Support

Name the tissue/ cartilage/ muscle with function and location and characteristics

Fibrous cartilage
Intervertebral discs, pubis bone
Shock absorption, support

Name the cartilage with location and function

Elastic cartilage
External ears, epiglottis
Support, resist compression

Name the type of bone
With location and function

Compact bone
Every bone
Support, protection, movement, mineral storage, blood cell formation, triglyceride storage
Identify the picture with location and function
Blood
Artery and veins
Supporting tissue and organs through body
Identify muscle type with function and location

Skeletal muscle
Found on skeletal muscles
Function: contracts to cause voluntary movement
Striated, multinucleated
Name the muscle type, with location and function

Cardiac muscle tissue
Heart
Movement of blood through body
Striated, intercalated discs

Name the tissue/ cartilage/ muscle, and give the location and function

Smooth muscle
Hollow organs and blood vessels
Movement (food through digestive, blood in artery/ veins)
Non striated
1 nucleus
Name the tissue with location and function

Nervous tissue
Nerves, spinal cord, brain
Relay electoral signals to communicate with brain
Name the tissue with location and function

Nervous tissue
Nerves, spinal cord, brain
Relay electoral signals to communicate with brain
What does epithelial tissue do?
Covers things exposed, lines organs
Primary tissue class
What does connective tissue do?
Provide support, under every epithelial tissue is connective tissue
Primary tissue class


